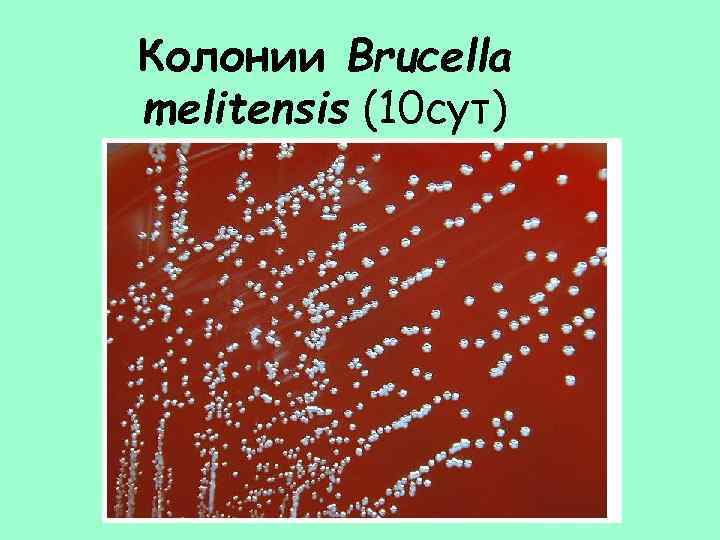
Колонии Brucella melitensis (10 сут)
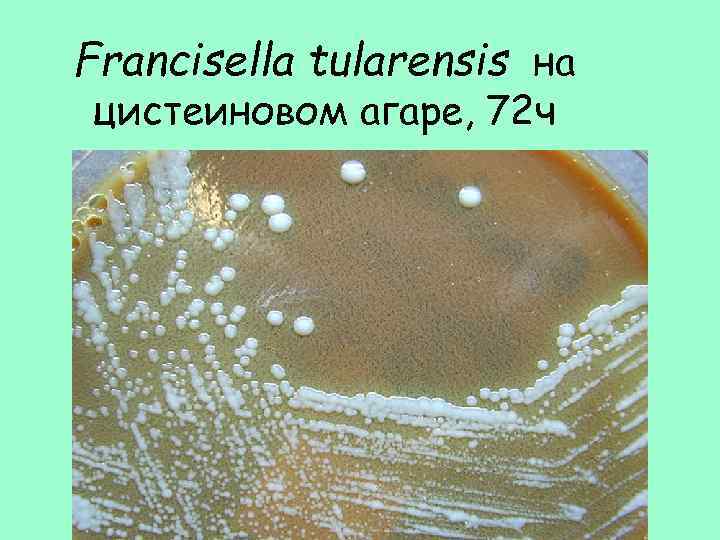
Francisella tularensis на цистеиновом агаре, 72 ч
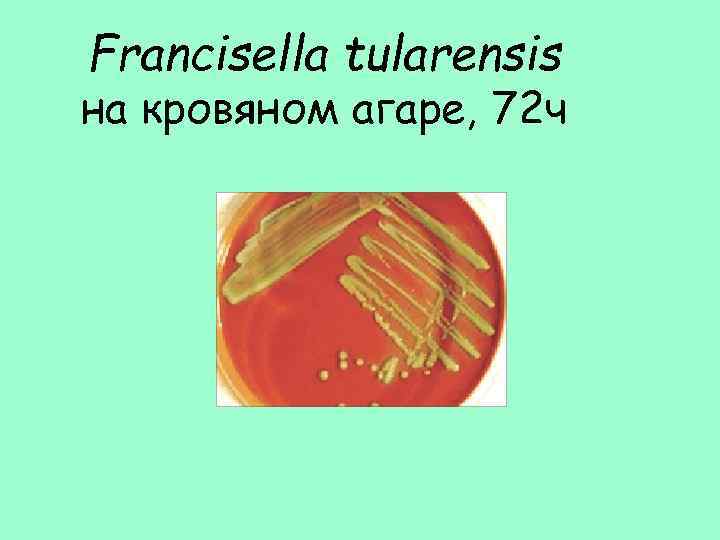
Francisella tularensis на кровяном агаре, 72 ч

5. бруцеллез, туляремия.ppt
- Количество слайдов: 54

Особо опасные инфекции • Всемирная организация здравоохранения объявила карантинными инфекциями международного значения 4 болезни: чуму, холеру, натуральную оспу (с 1980 г. считается искорененной на Земле) и желтую лихорадку (а также сходные с ней лихорадки Эбола и Марбург). • У нас в стране соответствующие эпидемиологические правила распространяются также на туляремию и сибирскую язву.

Бруцеллез

David Bruce (1855 -1931) Английский военный врач, Выделил чистую культуру бруцелл во время эпидемии на о. Мальта в 1887 г.

Бруцеллез – зоонозное инфекционное заболевание, вызываемое бактериями рода Brucella, характеризуется длительной лихорадкой, потливостью, поражением опорно-двигательного аппарата, а также поражением нервной, сердечно-сосудистой и мочеполовой систем.

КРС - крупный рогатый скот, МРС – мелкий рогатый скот


Таксономия • • • B. melitensis B. abortus патогены человека B. suis B. canis B. ovis не патогенны для человека B. neotomae

Источники инфекции

Устойчивость • • • Бруцеллы устойчивы во внешней среде: в воде - до 2 мес. и более, в брынзе - 2 мес. в сыром мясе - 3 мес. , в засоленном - 1 мес. , в шерсти - до 4 мес. • Кипячение убивает их моментально, нагревание при 60°С через 30 мин (благодаря чему пастеризация молока при 80°С в течение 20 мин гарантирует безопасность от заражения). • Мясо животных, больных бруцеллезом идет на консервы. • Бруцеллы чувствительны к действию обычных дез. средств.

Заражение человека от больных животных происходит: • • • контактным алиментарным аэрогенным путями Заражающая доза – 10 -100 м/клеток

Примерная частота данных анамнеза и некоторых симптомов/жалоб у больных бруцеллёзом (в %) Анамнез % больных Контакт с животными 74 Употребление в пищу свежего молока и сыра 70 Употребление в пищу сырой печени 29 Семейный анамнез бруцеллёза 38 Симптом/жалоба % больных Боль в животе 45 Диарея 7 Кашель 24 Сыпь на коже 14 Нарушение сна 37 Болезненный внешний вид 25 Бледность 22 Лимфаденопатия 32 Спленомегалия 25 Гепатомегалия 19 Желтуха 1 Нарушение функции ЦНС 4 Симптом/жалоба % больных Температура 93 Озноб, чувство холода 82 Потливость 87 Разлитые боли 91 Упадок сил, слабость 95 Боли в спине и связках 86 Артрит 40 Головная боль 81 Шум в сердце (эндокардит) 3 Потеря аппетита 78 Пневмония 1 Потеря веса 65 Запор 47

http: //krakow. telcom. pl/wp-content/uploads/2011/07/brucellosis-disease

Клинические формы 1. 2. 3. 4. 5. фаза лимфагенного заноса фаза генерализованной инфекции фаза многоочаговости фаза реактивно-аллергическая фаза остаточной инфекции или переход в хроническую фазу


Различают формы бруцеллеза: • острую (длительностью до 1, 5 - 3 мес. ), • подострую (3 - 6 мес. ), • хроническую (более 6 мес. ) • резидуальную (клиника последствий, сохраняющихся многие годы). Этапы патогенеза • • Лифоденопатия Аллергическая перестройка организма Хронизация инфекции Возможность образования L-форм

Развитие заболевания: • Характерно образование очаговых скоплений лимфо- и моноцитарных клеток в соединительнотканных образованиях многих органов (особенно в печени, селезенке), поперечно-полосатых мышцах, суставных сумках, связках (крупных суставов и позвоночника), а также в центральной и периферической нервной системе и эндокринных органах. Для бруцеллеза типично образование специфических гранулем, являющихся отражением защитной функции макрофагальной системы. • Сосудистые изменения наблюдаются в периферических отделах микроциркуляторного русла. Наблюдается повторная генерализация возбудителя, часто многократная, которая усиливает пролиферативные изменения в органах, ведущие к деформациям суставов, появлению различных соединительнотканных образований (фиброзиты, целлюлиты, тендовагиниты, бурситы и т. п. ). • Иммунитет при бруцеллезе формируется медленно, гуморальные его механизмы оказываются неэффективными. • Возможна реинфекция при повторном заражении - хроносепсис.

Бруцеллез Разрастание костной ткани http: //krakow. telcom. pl/wp-content/uploads/2011/07/brucellosis-disease

Поражение суставов у северного оленя, больного бруцеллезом B. rangiferi

Последствия бруцеллеза у людей полиартрит (боль в суставах, припухлость, ограничение подвижности).

Этапы заражения макрофага Brucella Размножение Brucella внутри ЭПС

Морфология Brucella 04 х 1, 0 мкм
Колонии Brucella melitensis (10 сут)

Биохимические свойства • Н 2 S • Каталаза+ • Уреаза+

Факторы патогенности • ЛПС - эндотоксин (лихорадка, потливость) • Ферменты: гиалуронидаза, фосфотаза • Факторы препятствующие слиянию фаго- и лизосом.

Лабораторная диагностика Диагностика складывается из: • бактериоскопических + • серологических методов + • • кожной пробы (Бюрне) + • бактериофаги ДИАГНОСТИКУМ БРУЦЕЛЛЕЗНЫЙ ЖИДКИЙ ДЛЯ РЕАКЦИИ АГГЛЮТИНАЦИИ, СУСПЕНЗИЯ ДЛЯ ДИАГНОСТИЧЕСКИХ ЦЕЛЕЙ НАБОР РЕАГЕНТОВ. БАКТЕРИОФАГИ БРУЦЕЛЛЕЗНЫЕ ДИАГНОСТИЧЕСКИЕ ЖИДКИЕ

Профилактика • Живая бруцеллезная вакцина (ревакцинация ежегодно) • АГ клеточной стенки

Чувствительность • гентамицин, тетрациклин, доксициклин (в течение 40 дней) • хуже левомицетин, стрептомицин. • лечение Бруцеллином по индивидуальным схемам • десенсибилизирующие средства (димедрол, супрастин, пепольфен, тавегил) • глюкокортикоидами, с назначением негормональных противовоспалительных средств (бутадион, диклофенак, бруфен, индометацин и др. ).

Возбудитель туляремии Francisella tularensis

• Открыт в 1910 г Mac’Coy и Chapin вблизи озера Туляре (США) • название в 1921 г. предложил американский бактериолог Эдвард Френсис (Francis Edward), выделил возбудителя и описал заболевание у людей.

Туляремия – зоонозное инфекционное заболевание с природной очаговостью, характеризуется лихорадкой и поражением лимфатических узлов в виде выраженного лимфаденита бубонного типа и поражением различных органов.

Эпидемиологическая ситуация

Эпидемиологическая ситуация • Ханты-Мансийский округ, посёлок Березово - с 8 августа 2014 г зарегистрировано 14 случаев заболевания туляремией, из них 5 детей (по неофициальным данным более 900 случаев). • 2009 г. Крым – 7 случаев туляремии • 2000 г. Косово – за месяц 659 случаев http: //86. rospotrebnadzor. ru/epidemiologic_situation/tulyaremia/-/asset_publisher/Qeq 4/content/ о-заболеваемости-туляремиеи-и-мерах-по-еепредупреждению http: //sitv. ru/arhiv/news/ugra/61085/

• • Туляремия Пути передачи Трансмиссивный Воздушный (тип А) Алиментарный Водный (тип В) От человека к человеку не передается!!!

Доноры, переносчики и реципиенты возбудителей туляремии

Способы заражения и развитие в организме человека Francisella tularensis

Устойчивость • В зерне, выделениях больных грызунов – до 4 мес. • В воде – до 3 мес. • Во льду – более 1 мес. • Прямые солнечные лучи – 30 мин. • 60 о. С – 10 мин. • Антисептики – 5 -10 мин.

3 клинические формы туляремии 1. наружная (с видимыми проявлениями) 2. висцеральная (поражение внутренних органов) 3. септическая (генерализованный процесс)

Туляремия, воспаление во входных воротах инфекции Характерные рубцы в зоне входных ворот инфекции

Больные ангинозно-бубонной и бубонной формой туляремии справа видны увеличенные подчелюстные лимфатические узлы

Кожно-бубонная (язвенно-бубонная) форма туляремии - увеличенные лимфатические узлы, стадия нагноения

Туляремия бубонная форма

Патогенез Francisella tularensis 1. Фагоцитоз 4. Апоптоз клетки и выход патогена 2. Выход из фагосомы 3. Размножение


Развитие Francisella tularensis в клетках печени мыши

Таксономия • F. tularensis • F. novicida – не патогенный

Francisella tularensis Морфологические свойства • Мелкие Гр- палочки • Длина 0, 2 -0, 7 мкм • Ширина 0. 2 мкм • Слизистая капсула у вирулентных штаммов

Francisella tularensis

Francisella tularensis Культуральные свойства Внутриклеточный паразит • • • Строгие аэробы Каталаза Образуют H 2 S t = 37 о. С р. H = 6, 7 - 7, 2 Степень ферментации варьирует (вирулентные штаммы образуют кислоту без газа)
Francisella tularensis на цистеиновом агаре, 72 ч
Francisella tularensis на кровяном агаре, 72 ч

Francisella tularensis ФАКТОРЫ ПАТОГЕННОСТИ: • ЭНДОТОКСИН • НЕЙРАМИНИДАЗА • Взаимодействие с Fc-фрагментами Ig. G, нарушение активности систем комплемента и макрофагов • Капсула Антигены: К и О Иммунитет длительный

Francisella tularensis Лабораторная диагностика: • • 1. бактериоскопия 2. биопробы на животных 3. посевы на спец. среды 4. серологические исследования (РНГА, РА, РСК, РИФ, ИФА) 5. аллергическая проба с тулярином НАБОР РЕАГЕНТОВ ТЕСТ-СИСТЕМА ДИАГНОСТИЧЕСКАЯ ДЛЯ ВЫЯВЛЕНИЯ ВОЗБУДИТЕЛЯ ТУЛЯРЕМИИ В ИММУНОФЕРМЕНТНОМ АНАЛИЗЕ (ИФА) ( «ИФА-Тул- Став. НИПЧИ» )

Профилактика • Дератизация • Живая вакцина Гайского-Эльберта – на 5 -7 лет (1946 г. СССР) • Вакцина туляремийная живая сухая

Francisella tularensis Чувствительность к АМП: • Стрептомицин, гентамицин !!! • Аминогликозиды • Эритромицин • Тетрациклин • Левомицетин
5. бруцеллез, туляремия.ppt